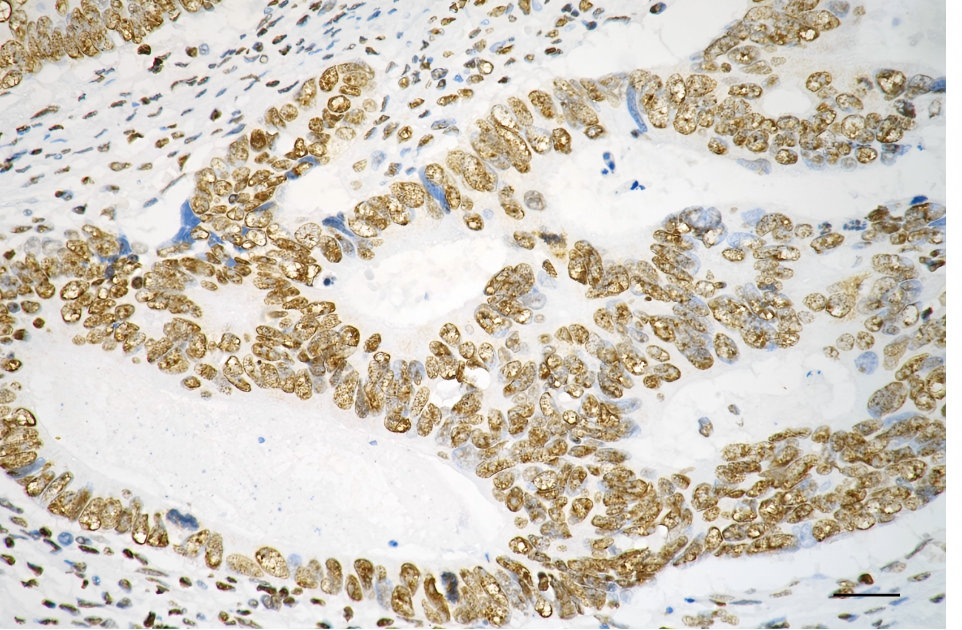

TAF15 Recombinant Monoclonal Antibody
-
中文名稱:TAF15 Recombinant Monoclonal Antibody
-
貨號:CSB-RA146447A0HU
-
規(guī)格:¥1320
-
圖片:
-
Flow cytometric analysis of TAF15 expression in HepG2 cells using TAF15 antibody. Green, isotype control; red, TAF15.
-
Immunocytochemical staining of HepG2 cells with TAF15 antibody. Nuclei were stained blue with DAPI; TAF15 was stained magenta with Alexa Fluor? 647. Images were taken using Leica stellaris 5. Protein abundance based on laser Intensity and smart gain: Medium. Scale bar, 20 μm.
-
Immunohistochemistry was performed on paraffin-embedded human sigmoid colon carcinoma using TAF15 antibody. Antigen retrieval was done in sodium citrate buffer (pH 6.0). DAB was used for detection, with hematoxylin counterstaining. Images were acquired using a Nikon Ci-L Plus microscope (40× objective). Scale bar: 25 μm.
-
Western blotting analysis using TAF15 antibody. Total cell lysates (30 μg) from various cell lines were loaded and separated by SDS-PAGE. The blot was incubated with TAF15 antibody and HRP-conjugated goat anti-rabbit secondary antibody respectively.
-
-
其他:
產(chǎn)品詳情
-
Uniprot No.:
-
基因名:TAF15
-
別名:TAF15; TATA-Box Binding Protein Associated Factor 15; RBP56; TAF2N; Npl3; TATA Box Binding Protein (TBP)-Associated Factor, RNA Polymerase II, N, 68kD (RNA-Binding Protein 56); TAF15 RNA Polymerase II, TATA Box Binding Protein (TBP)-Associated Factor, 68kDa; TATA-Binding Protein-Associated Factor 2N; HTAFII68; TAFII68; TATA Box-Binding Protein-Associated Factor 2N (RNA-Binding Protein 56); 68 KDa TATA-Binding Protein-Associated Factor; TBP-Associated Factor 15; RNA-Binding Protein 56; RBP56/CSMF Fusion; TAF(II)68
-
反應(yīng)種屬:Human, Mouse, Rat
-
免疫原:Recombinant Human TAF15 protein
-
免疫原種屬:Homo sapiens (Human)
-
標(biāo)記方式:Non-conjugated
-
克隆類型:Monoclonal
-
抗體亞型:Rabbit IgG
-
純化方式:Affinity-chromatography
-
克隆號:1F6
-
濃度:It differs from different batches. Please contact us to confirm it.
-
保存緩沖液:Rabbit IgG in PBS (pH 7.4) containing 50% glycerol, and 0.02% sodium azide.
-
產(chǎn)品提供形式:Liquid
-
應(yīng)用范圍:ELISA, WB, FC, ICC, IHC
-
推薦稀釋比:
Application Recommended Dilution WB 1:1000-1:5000 FC 1:200-1:2000 ICC 1:100-1:1000 IHC 1:100-1:200 -
Protocols:
-
儲(chǔ)存條件:Upon receipt, store at -20°C or -80°C. Avoid repeated freeze.
-
貨期:Basically, we can dispatch the products out in 1-3 working days after receiving your orders. Delivery time maybe differs from different purchasing way or location, please kindly consult your local distributors for specific delivery time.
-
用途:For Research Use Only. Not for use in diagnostic or therapeutic procedures.
相關(guān)產(chǎn)品
靶點(diǎn)詳情
-
功能:RNA and ssDNA-binding protein that may play specific roles during transcription initiation at distinct promoters. Can enter the preinitiation complex together with the RNA polymerase II (Pol II).
-
基因功能參考文獻(xiàn):
- weak, multivalent interactions between TAF15 fibrils and heptads throughout RNA pol II CTD collectively mediate complex formation. PMID: 28945358
- In human stem cell-derived motor neurons, the RNA profile associated with concomitant loss of both TAF15 and FUS resembles that observed in the presence of the amyotrophic lateral sclerosis (ALS)-associated mutation FUS R521G, but contrasts with late-stage sporadic ALS patients. PMID: 27378374
- In a cohort of youth at risk for bipolar disorder, pathway analysis showed an enrichment of the glucocorticoid receptor (GR) pathway with the genes MED1, HSPA1L, GTF2A1 and TAF15, which might underlie the previously reported role of stress response in the risk for bipolar disorder in vulnerable populations. PMID: 28291257
- Aggregation of FET proteins FUS, EWSR1, and TAF15 mediate a pathological change in amyotrophic lateral sclerosis. (Review) PMID: 27311318
- Studies provide evidence that FUS/TLS, EWS and TAF15 proteins play a major role in neurodegenerative disorders. (review). PMID: 27415968
- O-GlcNAc glycosylation stoichiometry of TAF15 PMID: 27903134
- RNA binding by TAF-15 is dependent upon structural elements in the RNA rather than sequence. PMID: 26612539
- our data suggest that TAF15 and TLS/FUS operate within similar but not identical hnRNP M-TET protein complexes to influence the transcriptional or post-transcriptional output of a particular cell type. PMID: 24474660
- Data indicate that distinct differences in proteins becoming Poly(ADP-ribose) PARylated upon various genotoxic insults are observed, exemplified by the PARylation of RNA-processing factors THRAP3 and TAF15 under oxidative stress. PMID: 24055347
- TAF15 depletion inhibits growth & increases apoptosis. Its knockdown affects many genes involved in cell cycle & cell death. Among these, targets of microRNAs generated from the onco-miR-17 locus were overrepresented. PMID: 23128393
- Data show that FUS and TAF15 locate to cellular stress granules to a larger extend than EWS. FET-protein stress granule association most likely is a downstream response to cellular stress. PMID: 23049996
- The existence of a functionally discrete subset of U1 snRNP in association with TAF15 was suggested and provided further support for the involvement of U1 snRNP components in early steps of coordinated gene expression. PMID: 22019700
- TAF15 plays a role in RNA transport and/or local RNA translation PMID: 22771914
- Missense mutations of TAF-15, an RNA-binding protein, were found in patients with amyotrophic lateral sclerosis, and gene conferred neurodegeneration when expressend in Drosophila. PMID: 22065782
- REsults suggest the possibility that alterations of TAF15 and EWS might also be involved in the pathogenesis of FUS proteinopathies such as ALS and FTLD. PMID: 21856723
- Rare translocation t(12;17)(p13;q12), this translocation has been reported in 25 cases and its putative molecular consequence, the formation of a TAF15-ZNF384 fusion gene, in only six cases. PMID: 21504714
- These results suggest that additional studies are needed to determine whether mutations in the TAF15 gene represent a cause of familial amyotrophic lateral sclerosis. PMID: 21438137
- Elevated TAF15 mRNA levels did not translate to strongly elevated protein levels, consistent with its infrequent occurrence as translocation partner in tumors. PMID: 21344536
- Our findings define a role for a tumor-specific TAF15 antigen in malignant processes. PMID: 20048082
- The transcription factor gene CIZ/NMP4 is recurrently involved in acute leukemia through fusion with either EWSR1 or TAF15. PMID: 12359745
- hTAF(II)68-mediated transactivation is linked to the cytoplasmic Src signal transduction pathway. The hTAF(II)68 protein can associate with the SH3 domains of several cell signaling proteins, including v-Src. PMID: 15094065
- The oncogenic effect of the t(9;17) translocation may be due to the hTAF(II)68-TEC chimeric protein and that fusion of the hTAF(II)68 NTD to the TEC protein produces a gain of function chimeric product. PMID: 18330902
- FUS, EWS and TAF15 proto-oncoproteins were targeted to stress granules induced by heat shock and oxidative stress PMID: 18620564
- Data demonstrate that arginine methylation of TAF15 by PRMT1 is a crucial event determining its proper localization and gene regulatory function. PMID: 19124016
- Data show that a fraction of human U1 snRNA specifically associates with the nuclear RNA-binding protein TBP-associated factor 15 (TAF15). PMID: 19282884
- These results suggest that caspase-mediated degradation may represent a novel regulatory mechanism that controls TAF15 and TAF15-CIZ/NMP4 activities. PMID: 19426707
顯示更多
收起更多
-
相關(guān)疾?。?/div>A chromosomal aberration involving TAF15/TAF2N is found in a form of extraskeletal myxoid chondrosarcomas (EMC). Translocation t(9;17)(q22;q11) with NR4A3.亞細(xì)胞定位:Nucleus. Cytoplasm. Note=Shuttles from the nucleus to the cytoplasm.蛋白家族:RRM TET family組織特異性:Ubiquitous. Observed in all fetal and adult tissues.數(shù)據(jù)庫鏈接:
Most popular with customers
-
-
Phospho-YAP1 (S127) Recombinant Monoclonal Antibody
Applications: ELISA, WB, IHC
Species Reactivity: Human
-
-
-
-
-
-